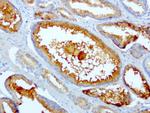
SDCBP Antibody in Immunohistochemistry (Paraffin) (IHC (P))

Search
OriGene
SDCBP Monoclonal Antibody (UMAB69), UltraMAB™
{{$productOrderCtrl.translations['antibody.pdp.commerceCard.promotion.promotions']}}
{{$productOrderCtrl.translations['antibody.pdp.commerceCard.promotion.viewpromo']}}
{{$productOrderCtrl.translations['antibody.pdp.commerceCard.promotion.promocode']}}: {{promo.promoCode}} {{promo.promoTitle}} {{promo.promoDescription}}. {{$productOrderCtrl.translations['antibody.pdp.commerceCard.promotion.learnmore']}}
产品信息
UM500057
种属反应
宿主/亚型
分类
类型
克隆号
抗原
偶联物
形式
浓度
纯化类型
保存液
内含物
保存条件
运输条件
靶标信息
The protein encoded by this gene was initially identified as a molecule linking syndecan-mediated signaling to the cytoskeleton. The syntenin protein contains tandemly repeated PDZ domains that bind the cytoplasmic, C-terminal domains of a variety of transmembrane proteins. This protein may also affect cytoskeletal-membrane organization, cell adhesion, protein trafficking, and the activation of transcription factors. The protein is primarily localized to membrane-associated adherens junctions and focal adhesions but is also found at the endoplasmic reticulum and nucleus. Alternative splicing results in multiple transcript variants encoding different isoforms.
仅用于科研。不用于诊断过程。未经明确授权不得转售。
篇参考文献 (0)
生物信息学
蛋白别名: MDA-9; mda-9; pbp-1; melanoma differentiation associated protein-9; Melanoma differentiation-associated protein 9; Pro-TGF-alpha cytoplasmic domain-interacting protein 18; Scaffold protein Pbp1; syndecan binding protein (syntenin); Syndecan-binding protein 1; Syntenin-1; TACIP18; unnamed protein product
基因别名: MDA-9; MDA9; SDCBP; SDCBP1; ST1; SYCL; TACIP18
UniProt ID: (Human) O00560
Entrez Gene ID: (Human) 6386